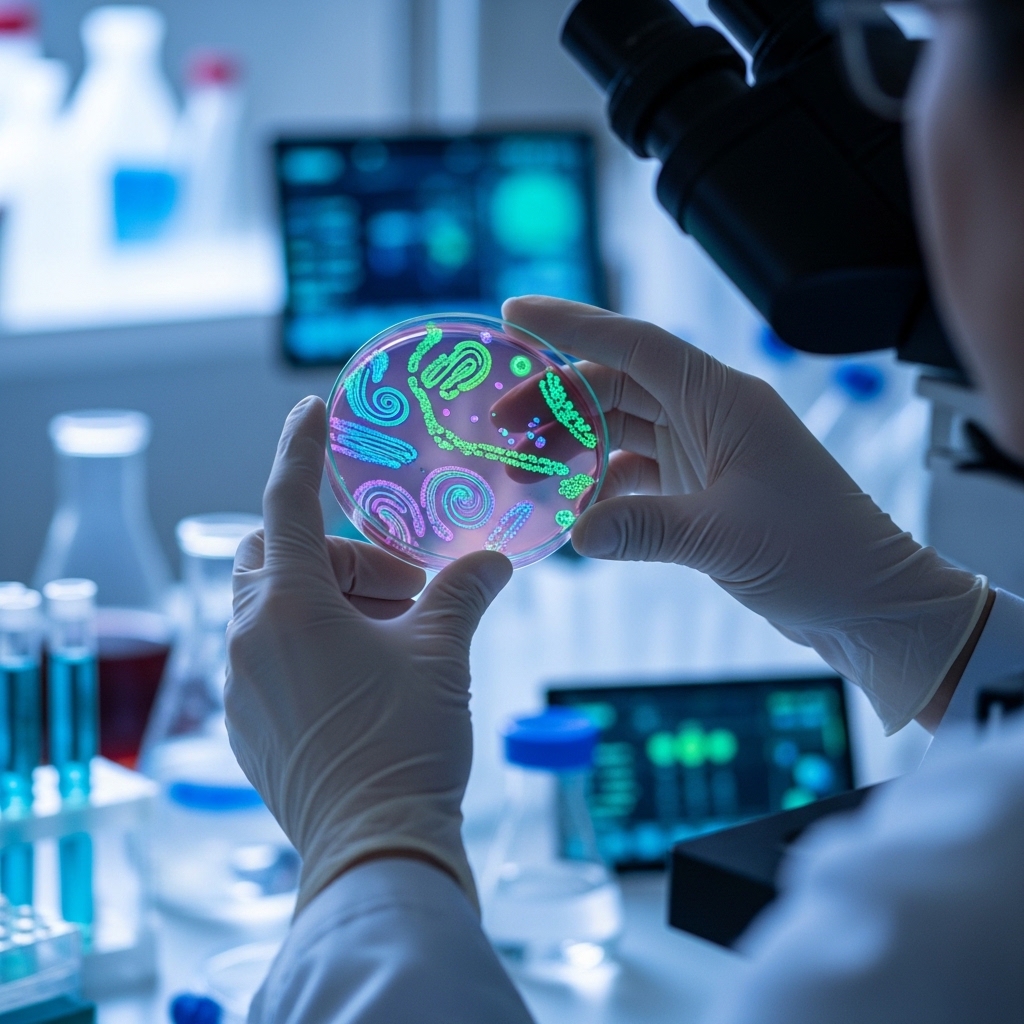

Gut microbiome disruption is a measurable performance liability for professionals operating under sustained cognitive and occupational demand. When dietary patterns chronically elevate pro-inflammatory cytokines — particularly IL-6 and TNF-α — the downstream consequences extend well beyond digestive discomfort. Systemic inflammatory burden impairs insulin sensitivity, accelerates biological aging, and degrades the neurochemical environment that executive cognitive function depends on. For professionals in the 35 to 60 age range, daily dietary choices are not a wellness consideration. They are a clinical variable.
The Gut Microbiome as a Biological System
The gut microbiome comprises trillions of microorganisms — bacteria, fungi, and viruses. Together, they regulate digestive function, immune response, and systemic inflammatory tone. Critically, this ecosystem is not static. It responds directly to what a person eats, how they move, how long they sleep, and how much chronic stress they carry. Research from the Human Microbiome Project confirmed that microbial composition varies significantly between individuals. It also shifts measurably within days in response to dietary change.
For professionals in the 35 to 60 age range, this responsiveness is both a risk and an opportunity. A microbiome under chronic dietary stress produces short-chain fatty acid deficits. It also increases intestinal permeability and elevates systemic inflammatory markers. Each outcome compounds the others. As a result, the biological environment accelerates cellular aging and degrades the performance systems that executive function depends on.
Understanding this system requires moving beyond “gut health” as a digestive concern. Rather, the microbiome operates as a systemic regulator. Its influence extends to immune function, neurochemical production, cortisol metabolism, and metabolic efficiency. Consequently, any professional managing high cognitive output and sustained occupational stress carries a measurable stake in its function.
Dietary Fiber as the Primary Microbial Substrate

Dietary fiber is the most evidence-backed nutritional input for microbiome health. Specifically, beneficial bacteria ferment soluble fiber into short-chain fatty acids — primarily butyrate, propionate, and acetate. These compounds reduce intestinal permeability and downregulate inflammatory cytokine production. They also support the mucosal barrier that separates gut contents from systemic circulation. Without adequate fiber, this fermentation process slows and microbial diversity declines.
Research published in Cell demonstrated that dietary fiber intake directly correlates with microbiome diversity. Furthermore, lower diversity consistently associates with higher systemic inflammation, impaired metabolic function, and elevated disease risk. The practical implication is direct: diets built around ultra-processed foods and refined carbohydrates starve the microbial populations that regulate inflammatory tone.
For professionals whose schedules favor convenience foods, this deficit compounds quietly. The effects are not immediate or dramatic. Instead, they accumulate across months and years — manifesting as elevated C-reactive protein, worsening insulin sensitivity, and reduced cognitive resilience. Whole grains, legumes, vegetables, and fruits each provide distinct fiber types. As a result, variety across these categories produces broader microbial support than any single high-fiber food.
Fermented Foods and Live Bacterial Introduction

Beyond fiber, fermented foods introduce live bacterial strains directly into the digestive environment. Yogurt, kefir, kimchi, sauerkraut, and miso each carry distinct microbial profiles. These interact with the existing gut ecosystem in measurable ways. A landmark study published in Cell by Stanford University researchers found that a high-fermented-food diet increased microbiome diversity. It also reduced markers of systemic inflammation across a sixteen-week intervention.
This finding carries direct relevance for professionals managing chronic occupational stress. Elevated cortisol disrupts gut barrier integrity. It also shifts microbial composition toward inflammatory phenotypes. Accordingly, introducing diverse bacterial strains through fermented foods provides a countervailing input. It does not eliminate stress physiology, but it reduces one of its measurable downstream effects.
Nevertheless, the practical barrier is consistency. Fermented foods require deliberate inclusion in daily eating patterns — particularly for professionals whose diets skew toward convenience. Even small daily servings provide cumulative microbial benefit when consumed consistently over weeks and months. Moreover, variety across fermented food types broadens the bacterial strains introduced, supporting a more resilient microbiome over time.
READ ALSO: Detox Body Cleanser to Ease You Into the New Season
Resistant Starches and Colon Health

Building on the fiber discussion, resistant starches represent a specific and clinically meaningful fiber category. Unlike digestible carbohydrates, they pass through the small intestine intact. They then reach the colon, where they serve as fermentation substrate for beneficial bacteria. Foods including green bananas, cooked and cooled potatoes, legumes, and whole grains all contain meaningful resistant starch concentrations.
Research from the National Institutes of Health links resistant starch intake to reduced colorectal cancer risk and improved insulin sensitivity. It also associates with more regular bowel transit. These outcomes result from butyrate produced during fermentation. Specifically, butyrate feeds colonocytes, reduces mucosal inflammation, and supports the integrity of the intestinal barrier.
For professionals managing metabolic function alongside cognitive performance, resistant starches carry a dual benefit. They support stable blood glucose by slowing carbohydrate absorption. They also reduce post-meal insulin spikes. In turn, this metabolic stability reduces the energy fluctuations that impair sustained cognitive output. Including resistant starch sources at lunch — when professionals most need afternoon cognitive steadiness — represents one practical application of this evidence.
Protein Distribution and Its Microbiome Implications

Protein intake affects the microbiome in ways that extend well beyond muscle synthesis. High animal protein diets — particularly those heavy in red and processed meat — shift microbial composition toward inflammatory phenotypes. These bacterial species produce pro-inflammatory metabolites including trimethylamine N-oxide (TMAO) and hydrogen sulfide. Notably, elevated TMAO correlates with increased cardiovascular disease risk in large cohort analyses, including research published by the Cleveland Clinic.
By contrast, plant-based protein sources — legumes, nuts, seeds, and whole grains — produce a different fermentation environment. They deliver protein alongside fiber, creating conditions that favor butyrate-producing bacteria over inflammatory phenotypes. Eliminating animal protein is not required. Rather, distributing protein across both animal and plant categories with deliberate regularity produces the relevant benefit.
Timing also influences outcomes independently. Distributing protein evenly across three to four daily meals supports more consistent muscle protein synthesis. It also moderates the metabolic load on the digestive system at any single meal. As a result, this supports gut motility and reduces the fermentation of undigested protein in the colon — a process that contributes directly to inflammatory metabolite production.
READ ALSO: Yeast Nutrition: A Quiet Gut Reset for the New Season
Ultra-Processed Foods and Inflammatory Dysbiosis

Ultra-processed foods represent one of the most direct dietary contributors to microbiome disruption. They are typically low in fiber and high in refined carbohydrates. They also contain emulsifiers, artificial sweeteners, and preservatives — each of which alters microbial composition in measurable ways. Research published in Nature found that certain emulsifiers disrupted the mucosal layer of the gut. Consequently, this increased intestinal permeability and triggered low-grade systemic inflammation.
For professionals, the relevance extends well beyond digestive symptoms. Intestinal permeability allows bacterial fragments to enter systemic circulation. This, in turn, activates immune responses that elevate IL-6 and CRP. These inflammatory markers impair insulin signaling, reduce neuroplasticity, and accelerate biological aging across multiple systems simultaneously.
The cumulative effect of high ultra-processed food intake is therefore not primarily a digestive problem. It is a systemic inflammatory problem with digestive origins. Reducing ultra-processed food consumption — shifting dietary composition meaningfully toward whole foods — produces measurable reductions in inflammatory markers within weeks. Controlled dietary intervention studies consistently support this outcome.
Hydration and Gut Motility

Alongside dietary composition, adequate hydration directly supports gut motility and mucosal integrity. Water facilitates the movement of food through the digestive tract. It also softens stool consistency and supports the mucus layer that protects the intestinal wall from bacterial contact. Chronic mild dehydration — common among professionals managing high workloads — slows bowel transit and alters microbial balance by concentrating intestinal contents.
A baseline of two to three liters of water daily provides a useful clinical reference point. Beyond this baseline, professionals who consume significant caffeine, travel frequently, or work in climate-controlled environments face heightened dehydration risk. Each of these conditions accelerates fluid loss or suppresses thirst signaling.
Importantly, hydration interacts directly with fiber intake. Dietary fiber requires adequate water to produce its motility benefits. A high-fiber diet consumed without sufficient hydration can worsen constipation rather than resolve it. For this reason, fiber and hydration operate as a functional pair. Each amplifies the other's effectiveness when maintained together consistently.
The Cortisol-Gut Axis

Chronic stress physiology does not remain contained to the neuroendocrine system. Rather, sustained cortisol elevation directly affects gut function through the brain-gut axis — a bidirectional communication network linking the central nervous system to the enteric nervous system. Elevated cortisol increases intestinal permeability, alters gut motility, and shifts microbial composition toward inflammatory phenotypes.
Research from the National Institutes of Health documents that psychological stress measurably reduces populations of Lactobacillus and Bifidobacterium. These are two bacterial genera strongly associated with immune regulation and mucosal protection. Critically, this reduction occurs independently of dietary change. As a result, professionals managing high occupational stress carry microbiome disruption risk even when their dietary patterns are otherwise sound.
For this reason, gut health management cannot be reduced to nutrition alone. Cortisol regulation through structured recovery functions as a direct gut health intervention. Consistent sleep timing, defined non-work periods, and brief daily parasympathetic activation practices each reduce cortisol-driven intestinal permeability. Additionally, diaphragmatic breathing activates the vagus nerve, directly modulating gut motility and reducing stress-driven microbiome disruption.
READ ALSO: Digestive Health: Learn to Love Your Gut
Sleep Quality and Microbial Circadian Rhythms

Beyond stress physiology, sleep quality exerts its own independent effect on microbiome composition. The gut microbiome operates on its own circadian rhythm — one that synchronizes with the host's sleep-wake cycle. Disrupting sleep architecture through insufficient duration, irregular timing, or circadian misalignment disrupts microbial circadian rhythms simultaneously. Research published in Cell Host and Microbe demonstrated that even two days of sleep disruption produced measurable shifts in microbial composition, including reductions in butyrate-producing species.
For professionals who consistently sleep fewer than seven hours, this disruption compounds across weeks and months. The resulting microbial imbalance elevates systemic inflammatory markers. It also reduces intestinal barrier integrity and impairs neurochemical production — including serotonin precursors that influence mood and cognitive tone.
Notably, consistent sleep timing appears to matter as much as sleep duration for microbiome stability. Professionals who maintain a consistent sleep and wake schedule demonstrate more stable microbial circadian patterns. This holds even when compared against those who sleep adequate hours but vary their schedule significantly across the week. Ultimately, the outcome is measurable in both microbial composition and inflammatory marker levels.
Movement as a Microbiome Modulator

In addition to dietary and sleep inputs, physical activity exerts a direct and independent effect on gut microbiome composition. Aerobic exercise increases microbial diversity and elevates butyrate-producing bacterial populations. It also reduces the ratio of inflammatory to anti-inflammatory microbial species. Importantly, these effects occur independently of dietary change — meaning movement modulates the microbiome through distinct biological mechanisms.
Research from the University of Illinois found that previously sedentary adults who completed six weeks of aerobic exercise showed significant increases in butyrate-producing bacteria. However, these increases reversed when exercise stopped. This reversibility underscores the importance of consistency. Movement produces microbiome benefits as an ongoing input, not a one-time intervention.
For professionals with limited exercise frequency, the evidence supports moderate-intensity aerobic activity as the most microbiome-relevant modality. Walking, cycling, and swimming at 50 to 70 percent of maximum heart rate produce measurable microbial benefits. Specifically, these benefits emerge at volumes as low as 150 minutes per week. This threshold is achievable without restructuring a professional schedule — but it requires consistent prioritization.
Evidence-Based Actions for High-Performing Professionals

Taken together, the evidence across nutrition, sleep, stress physiology, and movement converges on consistent themes. Increasing dietary fiber through whole grains, legumes, vegetables, and fruit supports microbial diversity and butyrate production. Additionally, adding fermented foods daily introduces live bacterial strains that reduce systemic inflammation. Distributing protein across animal and plant sources moderates inflammatory metabolite production. Maintaining hydration alongside fiber intake supports gut motility. Furthermore, sustaining seven to eight hours of sleep on a consistent schedule stabilizes microbial circadian rhythms. Incorporating 150 or more minutes of moderate aerobic activity weekly elevates butyrate-producing bacterial populations. Structured cortisol regulation — through recovery practices that activate the parasympathetic nervous system — reduces stress-driven microbiome disruption. Finally, periodic monitoring of CRP and IL-6 provides objective feedback on whether these behavioral inputs are producing measurable biological returns.
UP NEXT: Balanced Meals: Your Key to Optimal Health in 2025
Chronic gut microbiome disruption — driven by low dietary fiber intake, high ultra-processed food consumption, and poor sleep consistency — is a measurable accelerant of biological aging, with elevated inflammatory markers such as CRP and IL-6 directly linked to accelerated cellular senescence and a biological age that can run five or more years ahead of chronological age in individuals with sustained dysbiosis. WholeLiving's Biological Age Estimation Model incorporates this factor directly — your assessment takes under five minutes.
Ready to understand how these factors are influencing your biological age right now? [Take the Biological Age Assessment →]





